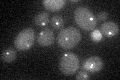
YAL047C
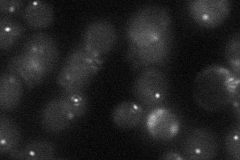
YAL047C

View description
Component of the cytoplasmic Tub4p (gamma-tubulin) complex, binds spindle pole bodies and links them to microtubules; has roles in astral microtubule formation and stabilization
Localization:
Intensity:
Fold change:
Significance:
-
C’ GFP library in SD
punctate17.67 -
N' NOP1pr-GFP in SD

punctate66.3024 -
N' TEF2pr-mCherry in SD

punctate9.90835 -
N' NATIVEpr-GFP in SD
punctate23.7214 -
N' TEF2pr-VC and Cyto-VN in SD

punctate39.8248 -
C’ GFP library in SD+DTT

punctate20.21.14No -
C’ GFP library in SD+H2O2

punctate23.471.32No -
C’ GFP library in Starvation Media

punctate19.791.12No -
C’ GFP library on the background of Pup2-DaMP

punctate -
C’ GFP library on the background of CCT mutant

punctate19.9641.12947No
